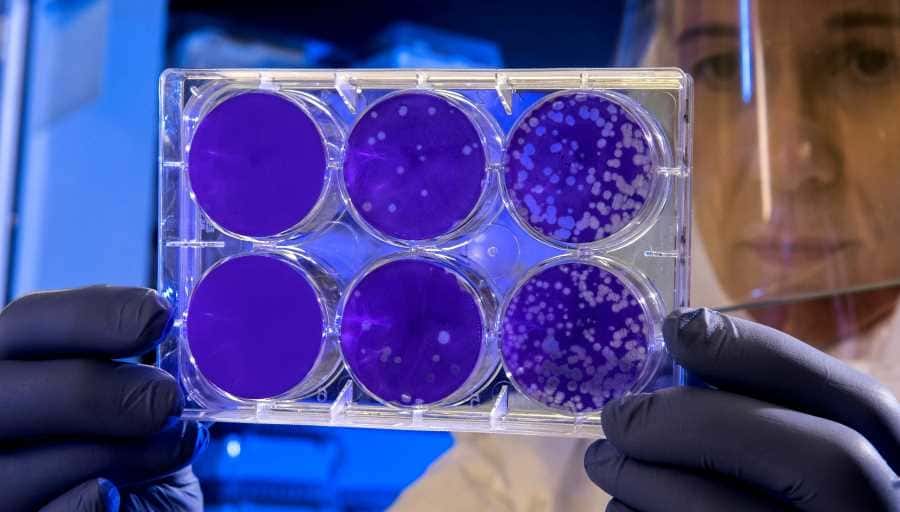
Gut microbiota can change with the carnivore diet – Copy The carnivore diet can change your gut microbiota

You have probably heard about the critical role that gut microbiome plays in human health and disease and that eating a variety of fruits, vegetables, fiber-rich food, and fermented food is good for gut health. The carnivore diet offers none of these. So what will the carnivore diet do to your gut microbiome?
Research in this area is very limited. Of the four relevant studies in this area that I can find, three indicate that a carnivore diet generally would not materially change your overall gut microbiome and one indicates that it may.
In the remainder of this post, we will briefly look at the carnivore diet and its logic, the gut microbiota and its role in human health and disease, and available research on the impact of a meat-based diet or a high protein diet on the gut microbiome.
The carnivore diet
What is the carnivore diet?
A carnivore is an animal that feeds on other animals. Therefore, strictly speaking, by definition, someone on the carnivore diet will basically just eat animal source food such as ruminant meat, pork, poultry, and seafood and drink water.
However, a broader version of the carnivore diet can include all foods that come from or are produced by an animal including ruminant meat (e.g. beef, lamb, goat, and bison), pork, poultry, seafood, eggs, dairy, and honey.
All plant foods such as fruits, vegetables, grains, legumes, seeds, and nuts are excluded from the carnivore diet.
What to eat on the carnivore diet?
On the carnivore diet, all you can eat are food from the animal kingdom. Some people reported doing well with just muscle meat and water. However, some advocates a nose-to-tail approach on this diet where one eats not just meat but also organ meats because they are considered the most nutrient-rich food.
Why did people start the carnivore diet?
People start the carnivore diet for many reasons including weight loss, treating health issues such as inflammation, autoimmune, gut issues, skin issues, metabolic syndromes.
The logic behind the carnivore diet
There are two main reasons why the carnivore diet makes logical sense to many people:
- The carnivore diet is consistent with our genetic make-up. Evidence from human physiology and genetics, archaeology, paleontology, and zoology show that humans were hyper-carnivorous apex predators that ate mostly meat from large animals for 2 million years. Living conditions and human behaviors have changed rapidly in recent time, but our genetic makeup remains virtually the same as that at the end of the paleolithic period. The human body is designed to eat meat still. [1, 2]
- Plant-based food is full of plant toxins. As plants are stuck to the ground and can’t defend themselves like the way animals do, to deter predators, they produce toxins, in their leaves, stems, flowers, seeds, and roots. Although plants can be full of nutrients, they are also full of toxins or natural pesticides.[3] It doesn’t make sense to eat plant food and consume these toxins while you can eat animal-based food that is nutrient-dense and free from toxins.
Evidence on the health implication of the carnivore diet
The most compelling evidence supporting the carnivore diet is mentioned above. The totality of evidence from human physiology and genetics, archaeology, paleontology, and zoology shows that our ancestors were exclusively meat-eaters for millions of years and thrived on this diet. [4]
In addition, some modern-day groups like the Canadian Inuit, the Maasai tribe from Kenya, the Gauchos in South America, the Mongolian nomads also follow either an exclusively animal-based diet or a heavily meat-based diet but appear to be healthy. [5, 6, 7, 8, 9]
Some of these traditional tribes who have transitioned to a more Western-style diet with an increase in processed food and refined carbohydrate intake have experienced increased health risks including poor dental health, diabetes, obesity, and heart diseases.[10, 11]
While there has been no recent scientific research on the health benefits and its associated risks, the carnivore diet has shot up in popularity thanks to anecdotal evidence. Many people have managed to lose weight, treats health problems that modern medicine has failed, and improve their general well-being on this diet.[12]
A clinic in Hungry, called The International Center for Medical Nutritional Intervention Clinic, has also been using a meat-based diet called ‘Paleolithic Ketogenic Diet’ to successfully treat an extensive range of autoimmune and metabolic diseases, such as type I diabetes, type II diabetes, cancer, and Crohn’s disease since 2013. [13, 14, 15, 16, 17, 18, 19, 20, 21, 22]
The gut microbiome
What is the gut microbiome?
The gut microbiome, also often referred to as the gut microbiota, are microorganisms that are found in the digestive tract of the human body. They include bacteria, viruses, fungi, and other microorganisms. So far, researchers have a much better understanding of the role of bacteria in human health and disease compared to other constituents of the microbiome.[23]
At birth, the entire intestinal tract is sterile. It begins to be colonized by maternal and environmental bacteria through the birthing process, feeding, drugs, and other contacts. By two and half years of age, the microbiome of an infant will fully resemble that of an adult. Thereafter, the composition of the intestinal microbiome is mainly influenced by age, diet, and antibiotics.[24, 25]
The role of gut microbiome in the human body
This is a relatively new area of research and we are only beginning to understand the role of the gut microbiome in health and disease in humans.
In a healthy individual, the gut microbiome has the following functions:[26, 27]
- Nutrient metabolism. The gut microbiome plays a significant role in the digestion and absorption of nutrients from dietary sources including digesting fiber, supporting vitamin synthesis, and breaking down of various polyphenols found in plant food
- Xenobiotic and drug metabolism. The gut microbiome can help metabolize xenobiotics (substances foreign to the human body) and drugs
- Antimicrobial protection. A healthy gut microbiome can both prevent the overgrowth of resident pathogens by competing with them while being tolerant to and supportive of the beneficial commensals
- Modulation of the immune system. The gut microbiome contributes to gut immunomodulation in tandem with both the innate and adaptive immune systems.
Substantial and adverse changes to the microbiome composition, a state known as ‘dysbiosis’, has been linked to various diseases including:[28]
- Obesity
- Hypertension
- Cardiovascular disease
- Diabetes
- Cancer
- Inflammatory bowel disease
- Gout
- Depression
- Arthritis
- Infant health
- Longevity.
What will the carnivore diet do to your gut microbiome?
There is no direct research evidence on the impact that the carnivore diet has on the gut microbiome in the long term. However, there is some research on the short-term impact of high meat or high protein diets on gut bacteria. We will look at those in detail below.
In summary, three studies found that high meat or high protein consumption had no material impact on the composition of the intestinal microbiome and one study found that short-term adoption of an animal-based diet altered microbial community structure.
1. Kohnert et al (2021)[29]
Study design
In this study, 53 healthy, omnivore, normal weights participants were randomly assigned a strict vegan diet or a meat-rich diet (150 g of meat per day) for 4 weeks. Fecal samples were collected at the beginning and at the end of the trial and were analyzed using gene amplicon sequencing.
Findings
It was found that the gut microbiota of the participants was overall not remarkably changed after the transition to a vegan diet or a meat-rich diet for four weeks.
However, there were a few mostly highly individual-dependent differences between the vegan diet and the meat-rich diet. Specifically, three genera, namely Coprococcus, Roseburia, and Blautia, mainly from the family of Lachnospiraceae, were found to be different between the vegan diet and the meat-rich diet after the 4-week trial:
- Coprococcus was found to be enriched in the vegan diet and depleted in the meat-rich diet in this trial. Coprococcus is reported to play a supportive role in mental health and is found to be depleted in the case of depression and in children with autism spectrum disorder and in neurodegenerative disorders such as Parkinson’s disease. Based on this evidence alone, a meat-rich diet seems to have a negative impact on gut health
- Roseburia was found to be enriched in the meat-rich diet and depleted in the vegan diet in this trial. Roseburia is reported to be a “marker of health” and found being depleted in a variety of diseases including irritable bowel syndrome, obesity, Type 2 diabetes, nervous system conditions, allergies, and Parkinson’s disease. Based on this evidence alone, a meat-rich diet seems to have a positive impact on gut health
- Blautia was found to be enriched in the vegan diet and depleted in the meat-rich diet. The role of Blautia in health and disease is controversial as some species appear to be healthy while others are harmful. Based on this evidence alone, we don’t know if a meat-rich diet has a positive or negative impact on gut health.
2. Moreno-Pérez et al (2018)[30]
Study design
In a randomized, controlled, double-blind pilot study, 24 males with a minimum of five years of regular endurance training and a frequency of five sessions per week minimum were recruited.
Participants in the control group were given 24-g sachets containing maltodextrin while those in the protein group were given identical sachets containing a blend of whey isolate (10 g) and beef hydrolysate (10 g).
Supplements were consumed once per day after training during the training days or before breakfast during non-training days, for 10 weeks.
Microbiota, water content, pH, ammonia, and short-chain fatty acids were analyzed in fecal samples, whereas malondialdehyde levels (oxidative stress marker) were determined in plasma and urine.
Findings
It was found that fecal pH, water content, ammonia, and short-chain fatty acids concentrations did not change, indicating that protein supplementation did not increase the presence of these fermentation-derived metabolites.
Similarly, protein supplementation had no impact on plasma or urine malondialdehyde (oxidative stress marker) levels. However, it increased the abundance of the Bacteroidetes phylum and decreased the presence of health-related taxa including Roseburia, Blautia, and Bifidobacterium longum. Thus, the authors concluded, long-term protein supplementation may have a negative impact on gut microbiota.
3. David et al (2014) [31]
Study design
In this study, the researchers prepared two diets: a “plant-based diet” and an “animal-based diet”. Ten volunteers were fed each diet for 5 consecutive days.
Subjects on the plant-based diet ate cereal for breakfast and precooked meals made of vegetables, rice, and lentils for lunch and dinner. Fresh and dried fruits were provided as snacks on this diet.
Subjects on the animal-based diet ate eggs and bacon for breakfast and cooked pork and beef for lunch. Dinner consisted of cured meats and a selection of four kinds of cheese. Snacks on this diet included pork rinds, cheese, and salami.
This study has the fewest number of participants and the shortest study period amongst the four studies summarized here.
Findings
The authors concluded that the short-term consumption of diets composed entirely of animal or plant products alters microbial community structure and overwhelms inter-individual differences in microbial gene expression.
The animal-based diet increased the abundance of bile-tolerant microorganisms (Alistipes, Bilophila, and Bacteroides) and decreased the levels of Firmicutes that metabolize dietary plant polysaccharides (Roseburia, Eubacterium rectale, and Ruminococcus bromii). Microbial activity mirrored differences between herbivorous and carnivorous mammals, reflecting trade-offs between carbohydrate and protein fermentation.
The findings of this study are contradictory to the findings in Kohnert et al (2021) mentioned above. Kohnert et al (2021) found no significant change in gut microbiota when subjects adopted a vegan or a meat-rich diet. Further, Roseburia, reported to be a ‘marker of health’ was enriched in the meat-rich diet. David et al (2014), however, found a distinct alteration of gut microbiota by diet, and Roseburia was decreased by the animal-based diet.
4. Hentges et al (1977)[32]
Study design
Ten volunteers completed a 4-month diet series consisting of 1 month each of a control diet, a meatless diet, a high-beef diet, and the same control diet. Fat and fiber contents were essentially the same in all four diets, but protein content was doubled during the high-beef diet.
During the 4th week on each diet, three stool specimens collected from each volunteer were analyzed for chemical composition and content of facultative, aerobic, and anaerobic bacteria.
Findings
It was found that high beef protein consumption had little effect on the composition of the intestinal flora. There were no significant differences in total counts of facultative and aerobic or anaerobic organisms in the feces when volunteers were on meatless or high-beef diets.
The data indicate that animal protein consumption has little effect on the fecal bacterial profile in humans.
Conclusion
In summary, of the four studies summarised above, one suggests that a meat-based diet can have a significant impact on gut microbiota and the other three suggest that it is unlikely to.
In short, given this is a relatively new area of research, we don’t yet know a lot.
My take on this question is this.
When you are on an animal-based diet, you will be creating a favorable environment for bacteria and other microorganisms that rely on animal-based food to survive.
When you follow a more plant-centered diet, you will be feeding the bugs that thrive on fiber, carbs, and polyphenols and those bugs will likely proliferate.
Accordingly, there can be a considerable difference in the composition of the gut microbiota when one transitions to the carnivore diet long term.
But would such a change be bad for your health?
I doubt it, considering the fact that many people have managed to completely reverse their health problems that modern medicine has no cure for such as autoimmune diseases.
If you would like to start the carnivore diet, check out this step-by-step guide and my extensive library of articles on all aspects of the carnivore diet.
Disclaimer: The information in this post is for reference purposes only and not intended to constitute or replace professional medical advice. Please consult a qualified medical professional before making any changes to your diet or lifestyle.